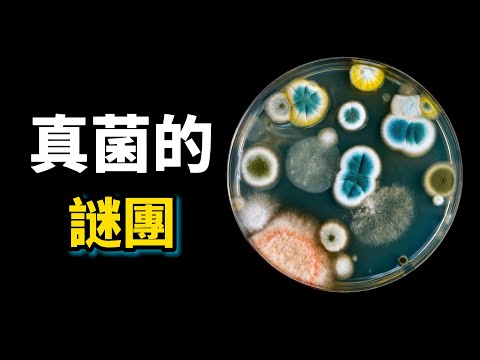
真菌之謎:輻射無法殺死的頑強生物,它們會發光,會吃掉活的昆蟲,還會淨化被石油污染的土壤,最昂貴的真菌63000美元一磅!

中法合拍纪录片!带你探索神秘的真菌王国 见证自然的微观奇迹《神奇的真菌世界》【CCTV纪录】
About
No channel description available.
Latest Posts
No results found. Try different keywords.
Video Description
■□欢迎订阅CCTV纪录■□www.youtube.com/@CCTVDocumentary 《神奇的真菌世界》https://www.youtube.com/playlist?list=PLwXMmy5fUrVxoNXa4tnuD8Y0SflSkfiiL https://www.youtube.com/playlist?list=PLwXMmy5fUrVzyQD17-YjqMAIZfIsQpc3Z ■□其他CCTV纪录精彩节目列表■□ https://www.youtube.com/playlist?list=PLwXMmy5fUrVxNUd50kxNjNF1V8S9dwLrj https://www.youtube.com/playlist?list=PLwXMmy5fUrVz_syY83H1cT6tTVKknOdEI https://www.youtube.com/playlist?list=PLwXMmy5fUrVy1i1NWbaTiQMnlxJyoLi03 https://www.youtube.com/playlist?list=PLwXMmy5fUrVwiFl0SLsra3s9ceJMG3M8A https://www.youtube.com/playlist?list=PLwXMmy5fUrVzYmdmYkLJ7WGs1MecTmJwt https://www.youtube.com/playlist?list=PLwXMmy5fUrVxw9oOVjeO2YWJ38TcgEdFs https://www.youtube.com/playlist?list=PLwXMmy5fUrVzzyCA1yF-aYA7ToE8_SX5F https://www.youtube.com/playlist?list=PLwXMmy5fUrVwEjiJ9sdT0WqLdtsC0xe9i https://www.youtube.com/playlist?list=PLwXMmy5fUrVxRDO8K8mLYfW9HIpqxiw0D https://www.youtube.com/playlist?list=PLwXMmy5fUrVwYouVOeKMql1BbBSYDOVr- https://www.youtube.com/playlist?list=PLwXMmy5fUrVz7efhizf3vsMo3DSwFiJ__ ■□Subscribe For More■□ CCTV中国中央电视台 www.youtube.com/@CCTV CCTV百家讲坛官方频道 www.youtube.com/@ChinaHistoryTalks CCTV电视剧 www.youtube.com/@CCTVDrama ■□Our Social Media■□ Facebook(中文)https://www.facebook.com/CCTV.CH Facebook(英文)https://www.facebook.com/cctvcom ■□更多精彩内容欢迎关注CCTV Global■□https://global.cctv.com/ #神奇的真菌世界 #纪录片 #菌子
Unveil the Fungal World with These Must-Have Essentials
AI-recommended products based on this video
